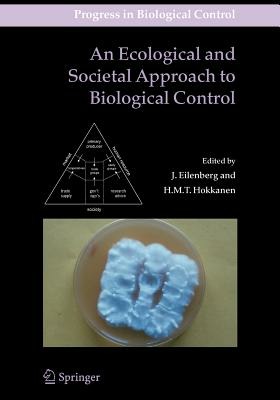
ibs

An Ecological and Societal Approach to Biological Control
Biological control is among the most promising methods for control of pests (including vectors), diseases and weeds. In this book ecological and societal aspects are for the first time treated together. In an ecological approach the aim is to evaluate the significance of certain biological properties like biodiversity and natural habitats. Also, it is important to see biological control from an organic (or ecological) farming point of view. In a societal approach terms like ‘consumer’s attitude’, ‘risk perception’, ‘learning and education’ and ‘value triangle’ are recognised as significant for biological production and human welfare.
-
Curatore:
-
Editore:
-
Collana:Progress in Biological Control
-
Anno:2010
-
Rilegatura:Paperback / softback
Le schede prodotto sono aggiornate in conformità al Regolamento UE 988/2023. Laddove ci fossero taluni dati non disponibili per ragioni indipendenti da Feltrinelli, vi informiamo che stiamo compiendo ogni ragionevole sforzo per inserirli. Vi invitiamo a controllare periodicamente il sito www.lafeltrinelli.it per eventuali novità e aggiornamenti.
Per le vendite di prodotti da terze parti, ciascun venditore si assume la piena e diretta responsabilità per la commercializzazione del prodotto e per la sua conformità al Regolamento UE 988/2023, nonché alle normative nazionali ed europee vigenti.
Per informazioni sulla sicurezza dei prodotti, contattare productsafety@feltrinelli.it